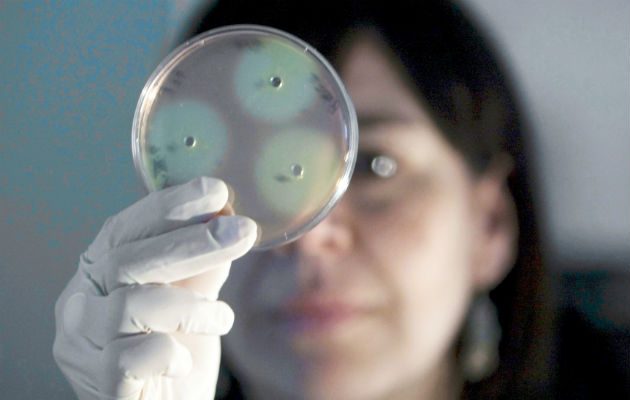
Las infecciones causadas por este Pseudomonas farmacorresistente en particular son raras en los Estados Unidos y son difíciles de tratar.

Viajeros de Estados Unidos son advertidos ante prevalencia de infecciones resistentes a antibióticos contraídas en México
- Roberto López Dubois
“El CDC ha recibido informes de infecciones graves por Pseudomonas aeruginosa en residentes de EE. UU. que tuvieron procedimientos médicos invasivos (principalmente cirugía para perder peso) en Tijuana, México”.
Las infecciones causadas por este Pseudomonas farmacorresistente en particular son raras en los Estados Unidos y son difíciles de tratar.
El centro de control de enfermedades de Estados Unidos (CDC, por sus siglas en inglés) emitió una alerta a sus ciudadanos que viajen a México a realizarse operaciones, especialmente para perder peso a la prevalencia de infecciones resistentes a los medicamentos contraídas en clínicas en México.
Un informe reciente del CDC señala que cerca de una docena de estadounidenses que viajaron a México para someterse a una cirugía regresaron al país con una infección resistente a los antibióticos. https://t.co/AmjTF3F8L5
— Telemundo Lubbock (@TelemundoLbk) 13 de enero de 2019
“El CDC ha recibido informes de infecciones graves por Pseudomonas aeruginosa resistentes a los medicamentos en residentes de EE. UU. que tuvieron procedimientos médicos invasivos (principalmente cirugía para perder peso) en Tijuana, México”, asegura el comunicado publicado en la página web del Center for Disease Contros and Prevention.
Agregan que casi mitad de las personas infectadas con estas bacterias se sometieron a una cirugía en el Grand View Hospital, Tijuana. Los otros se infectaron después de la cirugía en otros hospitales y clínicas. Las infecciones causadas por este Pseudomonas farmacorresistente en particular son raras en los Estados Unidos y son difíciles de tratar.
El CDC recomienda que los viajeros a México que no se sometan a una cirugía (incluida la cirugía para bajar de peso) en el Grand View Hospital en Tijuana, hasta que el gobierno mexicano pueda confirmar que la forma resistente a los medicamentos de la bacteria Pseudomonas aeruginosa ya no existe.
El CDC recomienda los visitante a otros países a recibir atención médico lo siguiente:
Algunas personas que han viajado para recibir atención médica a países fuera de los Estados Unidos han sido infectadas por cepas de bacterias resistentes a los antibióticos difíciles de tratar que no se ven comúnmente en los Estados Unidos.
Los procedimientos médicos y quirúrgicos realizados en cualquier lugar (incluso en los Estados Unidos) conllevan cierto riesgo y pueden dar lugar a complicaciones.
Consulte a un especialista en medicina de viajes en los Estados Unidos al menos un mes antes de su viaje. Los especialistas en medicina de viajes pueden brindarle la orientación, las vacunas y los medicamentos que pueda necesitar para su viaje.
Pregúntele a su médico si está lo suficientemente saludable como para viajar al extranjero para procedimientos médicos o quirúrgicos.
Investigue el proveedor de atención médica que realizará su procedimiento, así como la clínica u hospital donde recibirá la atención. Tenga en cuenta que los estándares para proveedores y clínicas en el extranjero pueden ser diferentes a los de los Estados Unidos.
Busque clínicas y hospitales acreditados por organizaciones internacionales. Recuerde que el uso de un centro acreditado internacionalmente no es una garantía de que su atención médica esté libre de complicaciones.
Solicite a la clínica o al hospital que le proporcionen copias de todos sus registros médicos. Si es posible, estos registros deben estar en inglés. Tráigalos con usted a cualquier cita de seguimiento que tenga.
VEA TAMBIÉN Colombia insta a Nicolás Maduro a respetar al Parlamento de Venezuela
Cada vez que viaje fuera del país, tenga en cuenta los problemas de salud y seguridad en su destino. También considere los riesgos adicionales que plantea viajar después de la cirugía:
Cualquier viaje prolongado después de la cirugía aumenta su riesgo de desarrollar coágulos de sangre en sus piernas. Evite viajar durante al menos 10 días después de la cirugía en su pecho o abdomen (barriga). La Sociedad Americana de Cirujanos Plásticos recomienda que los pacientes esperen a volar al menos 7-10 días después de someterse a procedimientos cosméticos en la cara o después de los tratamientos con láser.
Considere los riesgos de participar en actividades típicas de vacaciones después de la cirugía. Evite tomar el sol, tomar alcohol, nadar, hacer largos recorridos o participar en actividades o ejercicios vigorosos.



Para comentar debes registrarte y completar los datos generales.